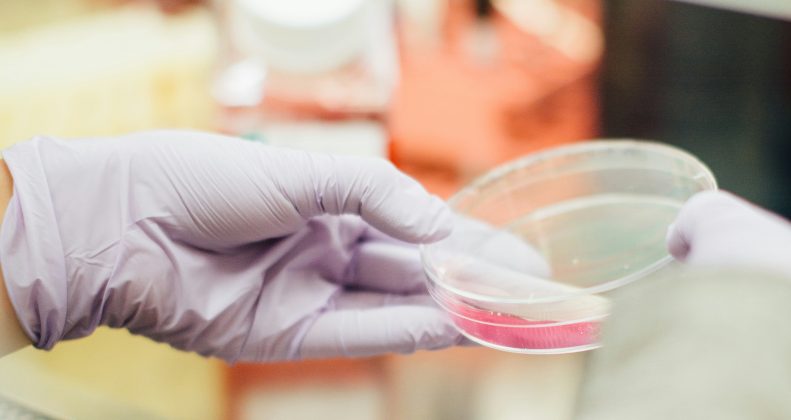

In this article, Amber Camilleri delves into Maltese medical jurisprudence concerning patient consent, specifically focusing on procedures related to Medically Assisted Procreation. It examines the legal and ethical requirements for obtaining informed consent from prospective parents, highlighting its importance as a cornerstone of medical practice and patient autonomy in Malta. It additionally outlines the rights […]
In this article, Michela Cutajar explores the evolving interpretation of Article 1030 of the Civil Code, the cornerstone of liability arising from the abuse of rights. It traces how Maltese jurisprudence has shifted from an early focus on neighbourly tolerance and the proper limits of exercising one’s rights, toward a modern approach centred on the […]
In this article, Martina Sammut critically examines the evolving relationship between state legitimacy and the moral obligation to obey the law and argues that legitimacy does not depend on a universal duty of obedience but rather on principles of normative power, consent, and fairness. Drawing on the works of theorists such as Raz and Edmundson, […]
In this article, Adele Gatt Livori explores the delicate balance between national security and freedom of expression under Article 10 of the European Convention on Human Rights. By examining key judgments such as Observer and Guardian, Bluf! and Big Brother Watch, it argues that the European Court of Human Rights has adopted an inconsistent and […]
In this article, Dr Karl Grech Orr and Dr Francesca Vassallo examine the Court of Justice of the European Union (CJEU)’s ruling in Joined Cases C-345/22, C-346/22, and C-347/22, addressing the enforceability of foreign jurisdiction clauses in bills of lading under the Brussels I Recast Regulation (Regulation (EU) No 1215/2012). The CJEU’s ruling confirmed that […]